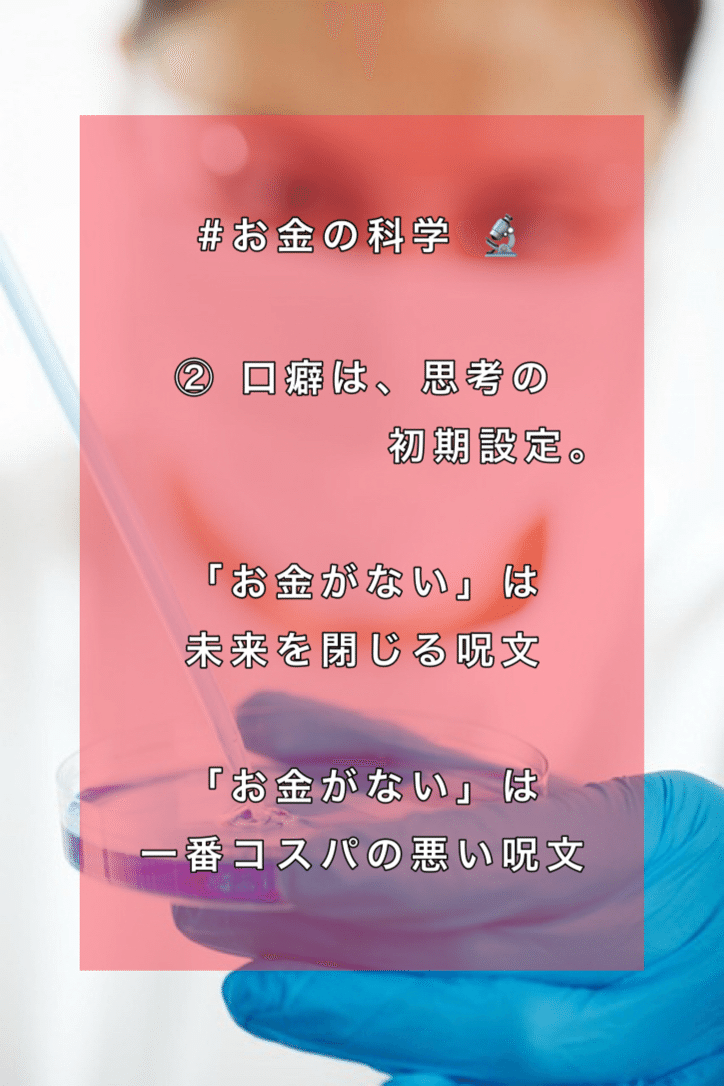
画像

1
hiroyukika3 (ひろゆきか〜)愛とお金のセラピスト
2026年1月30日 06:22
#お金の科学 🔬
― 言葉が、あなたの財布を決めている ―
お金の状態は、才能より「日常で使っている言葉」に強く影響される。
言葉 → 思考 → 行動 → 結果
この流れは、ほぼ自動運転です。
⸻
① お金に縁遠い人の「NG口癖」
これらは、脳に**“貧乏プログラム”をインストールする言葉**です。
❌「お金がない」
事実でも、繰り返すほど
👉「私は常に足りない人」という自己イメージが定着
👉 不安が強まり、短期思考&衝動的判断に。
❌「でも」「だって」「どうせ無理」
挑戦を始める前に終了させる言葉。
チャンスが来ても、脳が自動でシャットダウンします。
❌「もう歳だから」「私なんか」
自己肯定感を削り、
👉 行動量が減る
👉 結果、収入も情報も入ってこない。
❌「もったいない」(行き過ぎたケチ)
自己投資まで止めると、
👉 成長が止まる
👉 長期的に“高くつく人生”に。
⸻
② 言葉のクセが生む「お金に縁遠い行動」
#口癖 は、 そのまま行動になります。
• 🔻 安さ最優先 → 結局、買い直し
• 🔻 感情買い → ストレス発散=浪費
• 🔻 他責思考 「景気が悪い」「会社が悪い」
→ 自分の選択を見直さない
• 🔻 お金への悪印象 「金持ちはズルい」
→ 無意識に“豊かになる側”を避ける
⸻
③ 2026年 お金の科学的ヒント🔬
今年のキーワードは
「お金=管理するもの」ではなく「育てるもの」
✅ 言葉を変えるだけで行動が変わる
❌「お金がない」
⭕「今は〇〇のために使わない」
→ 不足 → 選択 に変わる。
✅ 家計は「お金の健康診断」
怖がるものではなく、
👉 体重計に乗る感覚で
👉 定期チェックするだけ。
✅ アファメーションは脳の再教育
「私はお金を上手に扱える」
「価値あるものに投資できる」
言葉は、脳の行動マニュアルです。
⸻
まとめ|お金は「言葉の扱い方」で決まる❓
💡 お金に縁遠い人
→ 言葉で自分を縛る
💡 お金と仲良くなる人
→ 言葉で未来を設計する
⸻
🔬2026年 お金の科学・最終結論
言葉を変えれば、思考が変わる。
思考が変われば、行動が変わる。
行動が変われば、通帳も変わる
厳しいけど事実。
お金は感情じゃなく
思考と言葉の習慣に集まる。
これは煽りじゃない。
現実を変える“最後のヒント”。
怒った人ほど
実は一番近い。
「変えられるのは“今の口癖”だけだから。」

あなたの口癖の成績表。
「お金がない」は
一番コスパの悪い呪文。

社会のせいにするほど
財布は軽くなる。

能力より先に
言葉が貧乏を作る。

口癖を変えない人は
一生、現実も変わらない。
ーーーー
ーーーー
愛とお金のセラピスト(ひろゆきか)の #カウンセリングノート
@hiroyukika.3
#JCCF #コーチカウンセラ
一般社団法人 日本コーチカウンセラー連盟
公認 シナジーコーチカウンセラー
https://jccf.site/
http://tsudahiroaki.com/univer/
https://note.com/hiroyukika3/n/ne0b3b10fe784









